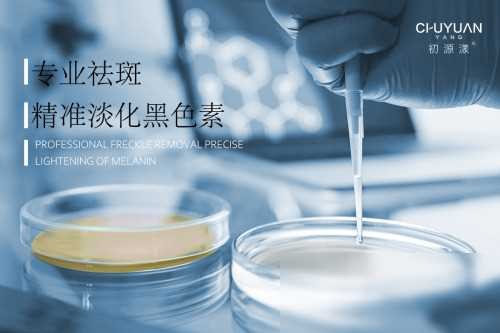

护肤品哪个牌子最好用?这几款,解锁肌肤的白皙密码
护肤品哪个牌子最好用?这几款,解锁肌肤的白皙密码
在当今社交媒体时代,人们对于美容护肤的追求已经成为了一种风潮。在各种平台上,各种各样的护肤品广告铺天盖地而来,声称自己是最有效的,能够带来白皙细腻的肌肤。而在这个充满选择的时代,消费者往往被眼花缭乱的产品选项所迷惑,不知道该如何选择适合自己的护肤品。因此,今天我们就来探讨一下,究竟哪些护肤品品牌能够解锁肌肤的白皙密码,让您拥有清透亮白的肌肤。

首先,我们不得不提的是资生堂这个拥有百年历史的日本品牌。资生堂一直以来都是护肤品市场的佼佼者,其产品线涵盖了各种各样的肤质需求,无论是清爽型、滋润型还是修护型,都有相应的产品推出。其中,资生堂的肌肤调理液备受好评,被誉为“面部精华水”的神器,使用后能够有效提亮肤色,使肌肤水嫩有光泽。

其次,LANEIGE(兰芝)作为韩国知名的护肤品品牌,在近年来也备受瞩目。兰芝的产品主打水润保湿,深受年轻人的喜爱。尤其是其经典的睡眠面膜,被誉为“一夜美肌”的救星,晚上敷上一层,第二天起床肌肤水润亮泽,仿佛换了一张脸。

另外,雅诗兰黛(Estée Lauder)也是护肤品市场上的一匹黑马。作为国际知名的美妆品牌,雅诗兰黛不仅在彩妆领域有着辉煌的表现,在护肤品领域也是名声在外。其经典的小棕瓶精华液,具有强大的抗氧化功效,能够修复肌肤损伤,延缓肌肤衰老,让肌肤重拾年轻光彩。
最后,我们来说说法国的兰蔻(Lancôme)。兰蔻作为法国的奢侈品牌,一直以来都以高端护肤品为主打,其产品更注重奢华感与护肤效果的结合。比如其著名的蓝色水合吧精华液,深受干性肌肤人群的喜爱,使用后肌肤变得柔软细腻,水润有光泽。

综上所述,护肤品市场上有许多品牌值得我们选择,资生堂、兰芝、雅诗兰黛和兰蔻都是不错的选择。然而,我们也要明白,每个人的肌肤状况不同,适合自己的护肤品才是最好的。因此,在购买护肤品时,一定要根据自己的肤质需求和肌肤问题做出选择,不要盲目跟风。

未来,随着科技的不断进步和人们对美的追求,护肤品市场将会



-
- 恋子情结有可怕?都以为拉丝母子自己火了,其实底下大妈才是亮点
-
2025-12-26 08:21:33
-
- 哪个银行自助机可以跨行存钱?
-
2025-12-26 08:19:19
-
- 我,公务员,告诉你在深圳当公务员工资多少?福利待遇很好吗?
-
2025-12-26 08:17:05
-
- 张爱玲:才华与悲剧交织的文学女神
-
2025-12-26 08:14:50
-
- 正月十五挂灯笼原来还有这么多的说法,挂不对反而起相反的作用!
-
2025-12-26 08:12:36
-
- 《我的世界》五款自动收割机配置介绍
-
2025-12-26 08:10:22
-
- 「3·15」疑似祛除眼袋手术失败,对方称没开过美容店
-
2025-12-26 08:08:07
-
- 2019年全国征兵工作即将开始!想参军要满足这些条件
-
2025-12-26 08:05:53
-
- "白冰:演艺圈中的耀眼明珠"
-
2025-12-26 08:03:39
-
- 便宜好用的智能手机,2024年四款高性价比手机推荐
-
2025-12-26 08:01:24
-
- 残忍屠杀:回顾1998年印尼雅加达排华事件!
-
2025-12-26 07:59:10
-
- 大美雄安绿色新城——雄县
-
2025-12-26 07:56:56
-
- 带你了解20世纪步兵武器之王“RPG火箭筒”,游击队手中的神器!
-
2025-12-26 07:54:41
-
- 好用的剃须刀有哪些?超靠谱的男士剃须刀十大品牌排名揭晓
-
2025-12-26 07:11:58
-
- 广东惠州十大景点有哪些?自驾游玩如何安排行程路线?
-
2025-12-26 07:09:53
-
- 中国十一大暑假旅游热门城市 暑假去哪里旅游好 这几个城市不容错过
-
2025-12-26 07:07:49
-
- 一文读懂金融行业十大证书
-
2025-12-26 07:05:45
-
- 春节起源大揭秘!那个让司马迁都折服的西汉奇人
-
2025-12-26 07:03:41
-
- 揭秘纵横新疆数十年的“巨匪”乌斯满最后岁月
-
2025-12-26 07:01:36
-
- 中国十大古典喜剧
-
2025-12-26 06:59:32



中国十大黑恶县城(中国十大黑恶县城有哪些)
【石井四郎的女儿还在吗】石井四郎女儿石井春海怎么死的?
元世祖忽必烈,一个在中国历史上留下了深刻印象的人物
世界上最贵的香烟,好彩香烟(60万一盒)
中国最严格的监狱(中国最严监狱排名)
中国最穷的十大城市,排名第一的是贵阳
中国“素质最差”三个省排行,国内“素质最差”省有哪些
中国最狠十大监狱(女子监狱怎么解决需要)
中国十大超穷省会城市排行榜 贵阳第一
十大抗日小说排行榜 让你热血澎湃的经典之作